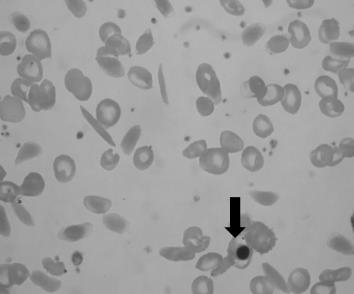
Enunciado 2956405-1

Foram encontradas 420 questões.
- SUSLei 8.080/1990: Lei Orgânica da SaúdeSistema Único de SaúdePrincípios, Objetivos, Diretrizes e Atribuições.Art. 7º: Princípios e Diretrizes
Pelos princípios do SUS, de acordo com a Lei nº 8.080/90, a regionalização e hierarquização da rede de serviços de saúde são princípios diretamente associados à:
Provas
- SUSLei 8.080/1990: Lei Orgânica da SaúdeSistema Único de SaúdePrincípios, Objetivos, Diretrizes e Atribuições.Art. 7º: Princípios e Diretrizes
Analise os itens abaixo, extraídos da Lei Orgânica de Saúde nº 8.080/90:
I- Identificação e divulgação dos fatores condicionantes e determinantes da saúde;
II- Divulgação de informações quanto ao potencial dos serviços de saúde e a sua utilização pelo usuário;
III- Capacidade de resolução dos serviços em todos os níveis de assistência;
IV- Controle da prestação de serviços que se relacionam direta ou indiretamente com a saúde.
NÃO SÃO princípios do Sistema Único de Saúde os citados em:
Provas
O parágrafo 5 do artigo 39 da Lei Orgânica de Saúde nº 8.080/90 relata que a cessão de uso dos imóveis de propriedade do Inamps para órgãos integrantes do Sistema Único de Saúde (SUS) será feita de modo a preservá-los como:
Provas
- SUSLei 8.080/1990: Lei Orgânica da SaúdeSistema Único de SaúdePrincípios, Objetivos, Diretrizes e Atribuições.Art. 7º: Princípios e Diretrizes
Princípio do Sistema Único de Saúde (SUS) que determina que a saúde é direito de cidadania e dever do Governo nas esferas municipal, estadual e federal:
Provas
Historiadores da arte afirmam que a ópera surgiu na Itália no século XVII e faz parte da tradição da música clássica europeia e ocidental. Sobre esse tema é CORRETO afirmar:
Provas
A música é formada por diferentes elementos. Por exemplo:
-
I- A organização de uma sequência dos sons;
II- Duração de um som.
-
Assinale a alternativa que relaciona CORRETA e respectivamente os termos acima.
Provas
Leia as definições hematológicas, abaixo:
- Hemácias em Rouleaux: Hemácias "empilhadas" devido a hiperproteinemia sérica, tal como acontece na hipergamaglobulinemia (tanto policlo-nal como monoclonal).
- Hemácias Crenadas: Hemácias em "forma de chapéu mexicano", com a presença de um centro escuro cercado por um halo claro que por sua vez é cercado por um halo com hemoglobina, dando a forma de um alvo. Aparecem na anemia ferropriva, em algumas hemoglobinopatias (talassemias, hemoglobina C) e hepatopatia crônica.
- Pontilhado Basófilo: Inclusões basofílicas que podem ser vistas em pacientes com hemólise, intoxicação por chumbo, talassemia, eritroenzimopatia (deficiência de Pirimidina 5´- Nucleotidase).
- Corpúsculos de Howell-Jolly: Inclusões basofílicas nas hemácias que ocorrem em estados de asplenia / hipoesplenismo (exemplos: esplenectomia cirúrgica, auto-esplenectomia na Anemia Falciforme). São remanescentes de material nuclear basofílico que deveria ser retirado pelo baço.
É CORRETO afirmar que entre as definições:
Provas
Das complicações ligadas à anemia falciforme, a hiperplasia da medula óssea leva a:
Provas
Observe a imagem:
No diagnóstico da anemia falciforme, alguns achados são observáveis no esfregaço de sangue periférico. O indicado pela seta denomina-se:
Provas
No diagnóstico da Leucemia Mieloide Aguda, no adulto, Mieloperoxidase e Negro de Sudam são classificados como métodos de:
Provas
Caderno Container